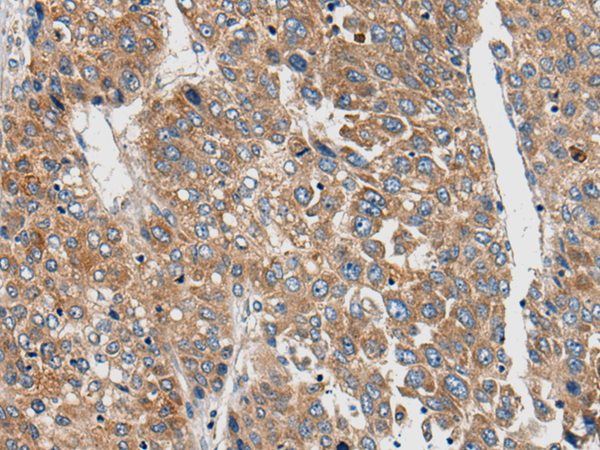

中文名稱: 兔抗CNTN5多克隆抗體
|
Background: |
The protein encoded by this gene is a member of the immunoglobulin superfamily, and contactin family, which mediate cell surface interactions during nervous system development. This protein is a glycosylphosphatidylinositol (GPI)-anchored neuronal membrane protein that functions as a cell adhesion molecule. It may play a role in the formation of axon connections in the developing nervous system. Alternatively spliced transcript variants encoding different isoforms have been described for this gene. |
|
Applications: |
ELISA, IHC |
|
Name of antibody: |
CNTN5 |
|
Immunogen: |
Synthetic peptide of human CNTN5 |
|
Full name: |
contactin 5 |
|
Synonyms: |
NB-2; HNB-2s |
|
SwissProt: |
O94779 |
|
ELISA Recommended dilution: |
5000-10000 |
|
IHC positive control: |
Human liver cancer and human ovarian cancer |
|
IHC Recommend dilution: |
25-100 |
購物車
幫助
021-54845833/15800441009
